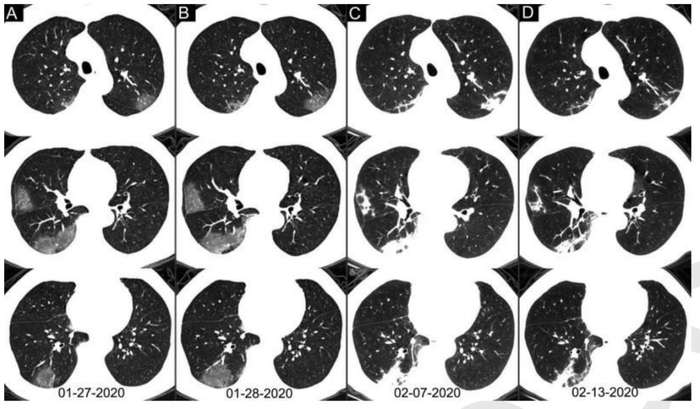

原标题:CT与核酸检测哪个更靠谱?看这篇文章就够了
原创 孙丹雄 医学界呼吸频道

出来"混"~单打独斗是不可取的!
2019新型冠状病毒(COVID-19),目前国际上很多学者称之为SARS-CoV-2(SARS冠状病毒2)。因为有些患者并无肺炎,所引起的疾病叫新型冠状病毒疾病更妥当。但是,这个名字比较拗口,简称为“新冠肺炎”更简洁、更通俗易懂。
经过全国人民一个多月的艰苦奋斗,现在除了湖北省,疫情基本稳住了,多个地区持续无新增病例。以前可以通过询问病史“是否来自湖北?是否接触感染者”等发现疑似病例,但是目前现存确诊患者减少、接触者被隔离,随着复工大潮的来领,感染途径将不容易追查,筛查新冠肺炎变得更加不容易。
筛查新冠病毒感染,选择胸部CT还是核酸检测?武汉同济医院最近对1014例感染者进行回顾性研究发现,胸部CT诊断新冠肺炎的敏感性高达97%,我们该如何看待这个研究呢?
研究内容
由于标本的类型、采集方法、运输以及试剂盒性能局限性等各种因素的影响,RT-PCR(为了阅读起来通俗易懂,以下简称核酸检测)筛查新冠肺炎的阳性率并不十分理想,咽拭子核酸检测的总阳性率约为30%~60%,有时并不能满足临床的需要。
纳入病例:2020年1月6日至2月6日,武汉地区的1014例同时行胸部CT和核酸检测的患者。以核酸检测为参考标准,评估胸部CT诊断新冠肺炎的价值。胸部CT和核酸检测之间的时间间隔超过7天的患者排除研究。
在1014名患者中,59%(601/1014)的患者核酸检测阳性,而88%(888/1014)的患者胸部CT阳性。核酸检测阴性的患者中,胸部CT检查阳性者占75%(308/413)。
结合核酸检测和CT扫描分析,核酸检测从阴性到阳性的平均间隔时间为5.1±1.5天(范围4~8天),核酸检测从阳性转为阴性的平均间隔时间则是6.9±2.3天(范围4~15 天)。
胸部CT敏感性
选择核酸检测阳性患者进行分析,601位确诊患者中580例(97%)胸部CT阳性,胸部CT诊断新冠肺炎的敏感性高达97%(95%CI:95-98%)。
60~93%的病例在初始核酸检测阳性之前(或同时)具有与新冠肺炎一致的初始CT阳性表现。42%(24/57)的病例在核酸检测结果转为阴性之前,其胸部CT扫描已经显示病灶吸收。
新冠肺炎很多患者是干咳,采集痰液困难,行支气管肺泡灌洗液检查更是不现实,而咽拭子核酸检测的总阳性率约为30%~60%,由此可见,筛查新冠肺炎胸部CT更具优势。
胸部CT的特异性
以核酸检测结果为参考,胸部CT诊断新冠肺炎的特异性、准确性分别为25%(95%CI :22-30%,105/413例)、68%(95%CI :65-70%,685/1014例)。
这个就尴尬了,胸部CT诊断新冠肺炎的特异性仅有25%,意思就是胸部诊断的新冠肺炎,只有25%的患者最后被确诊为新冠肺炎,75%的患者是其他疾病。
胸部CT检查 VS 核酸检测
核酸检测敏感性欠佳,咽拭子核酸检测的总阳性率约为30%~60%,意味着可能会漏诊40%~70%的患者,但是特异性好,核酸检测阳性目前可以说100%是感染了新冠病毒。
胸部CT检查敏感性好,高达97%,只漏诊了3%的患者,但是特异性差,仅有25%,意思就是胸部诊断的新冠肺炎,只有25%的患者最后被确诊为新冠肺炎,75%的患者是其他疾病。
简而言之:核酸检测敏感性差、特异性好、容易漏诊;胸部CT敏感性好,特异性差,容易误诊。
如何选择?
胸部CT和核酸检测,不存在谁好谁差,只能根据临床表现,具体选择。
西藏一片净土,只需要问一句,哦,不用问,听口音是外省人就可以筛查了。
武汉患者较多,单凭核酸检测容易漏诊,CT筛查更有优势,可尽早发现患者、尽早隔离、尽早处理、尽早治疗。
1月前,云南贵州青海等地患者较少,个个去做CT恐怕不妥,问一句是否来自湖北即可完成初步的筛查。
现在武汉封城1月余,潜伏期已过,寻找潜伏的感染者比较困难,需要综合流行病学史、症状、实验室检查综合分析,必要时进一步行胸部CT,或联合核酸检测。
目前青海清零,甘肃、宁夏的现存患者是个位数,很多省份的患者不足100,门诊常规进行胸部CT检查是否妥当,需要商榷,需要进一步研究。核酸检测敏感性低,但是没有辐射,特异性好,若能普及,我觉得更为妥当。
新冠肺炎影像学
无论何时,影像学都是发现病毒性肺炎的重要工具,认识新冠肺炎的影像学极其重要。虽然很多省份现存患者较少,但是,仍然不能掉以轻心。
典型的新冠肺炎影像学并不难,诊断的关键是:
早期出现小斑片或间质性改变,常有磨玻璃阴影;
病灶主要位于胸膜下。随着病情进展,病灶常为双肺多发。




随着病情进展,CT失去特异性,不容易鉴别与一般的肺炎。

特别是后期变成“白肺”,没有之前的影像学做对比,更是没办法做出准确的诊断。
下面这个患者,右下叶病灶,既无磨玻璃,又不在胸膜下,依靠CT诊断新冠肺炎几乎不可能。

影像学鉴别
诊断一个疾病,从来都是需要医生综合分析,特别是对于广大基层医院,单纯依靠影像学发现新冠肺炎,十分困难。很多疾病都可以表现为胸膜下为主的病灶。
▎流感
流感,特别是甲流,也会表现为胸膜下为主的磨玻璃,但是出现的几率小于新冠肺炎。
下面的患者,就是甲流病毒性肺炎。



▎坠积效应
睡着做CT,背部的肺会被压缩,形成胸膜下条形模糊影,反过来睡,病灶会消失。
▎其他类型的肺炎
很多肺炎都会表现为胸膜下为主的病灶,需要结合病情具体分析。
下图是肺曲霉感染。

下图是隐球菌感染。

▎间质性肺炎
很多间质性肺炎都会表现为胸膜下为主的病灶,特别是隐源性机化性肺炎,需要结合临床表现具体分析。
下图是嗜酸细胞性肺炎。

▎其他
百草枯中毒有时也表现为胸膜下磨玻璃阴影。

由此可见,随着疫情的控制,筛查新冠肺炎将面临新的困难,胸部CT检查仍然十分重要,但临床医生需要综合临床表现综合分析。
参考文献:
[1].Tao Ai*, Zhenlu Yang*, Hongyan Hou, Chenao Zhan, Chong Chen, Wenzhi Lv, Qian
Tao, Ziyong Sun, Liming Xia .Correlation of Chest CT and RT-PCR Testing in Coronavirus Disease 2019 (COVID-19) in China: A Report of 1014 Cases.https://doi.org/10.1148/radiol.2020200642.
[2].陈雀芦,都继成,李甫春,陈宇,敖利,胡文超.甲型H1N1流感并发肺炎的影像诊断[J].实用医学杂志,2011,27(7):1245-1247.
[3].周妍,陈莹莹,谭明旗,郑锐.甲型H1N1流感流行期间不明原因肺炎的CT影像表现[J].医学影像学杂志,2010,20(12):1799-1802.
[4].吴挺挺,丁群力,马红映,虞亦鸣,吕丹,邓在春.甲型流感合并肺炎影像学与疾病严重程度参数的相关性[J].中华结核和呼吸杂志,2019,42(1):50-52.
[5].李红敏,张倩倩,钱伟军.20例隐源性机化性肺炎的影像特点分析[J].中国CT和MRI杂志,2018,16(11):62-64.
[6].南喜文,唐光健,彭泰松,许志高,徐建国,李东春,高永莉,郝宝堂,高立伟.CT肺坠积效应与气道阻力关系的初步研究[J].中华放射学杂志,2015,49(3):183-185.
[7].陈蕾 刘辉国 刘威 刘静 刘馗 尚进 邓燕 魏双.2019新型冠状病毒肺炎29例临床特征分析.中华结核和呼吸杂志, 2020,43(00) : E005-E005.
[8].张明强 王小辉 安宇林 陈凯丽 赵景全 蔡存良 林明贵 牟向东.2019新型冠状病毒肺炎早期临床特征分析.中华结核和呼吸杂志, 2020,43(00) : E013-E013.
[9].杨菁菁,张旻,方芳,谭晓明,郭岩斐.病理确诊药物诱导的肺嗜酸细胞增多症1例并文献复习[J].中国医刊,2019,54(6):622-625.
本文首发:医学界呼吸频道
本文作者:云南省一医院 孙丹雄
责任编辑:施小雅


